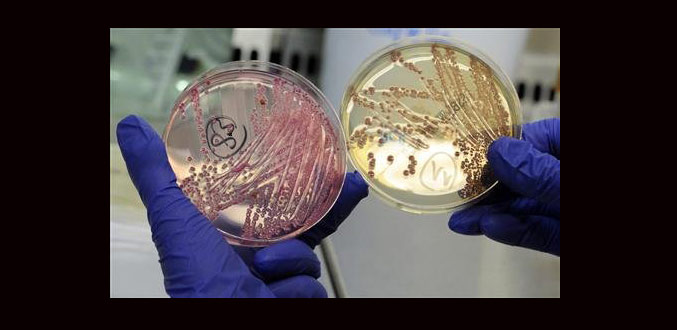

Reuters

9 juin 2011 20:00
Allemagne : Les graines germées à l''origine de l''épidémie d''E. coli

9 juin 2011 20:00
La nationalité française par mariage sera plus dure à obtenir

8 juin 2011 20:00
Allemagne : Le ralentissement de l''épidémie de bactérie E. coli se confirme

7 juin 2011 20:00
Pérou : le nouveau président dit qu''il n''imitera pas Chavez

7 juin 2011 20:00
La France et la Grande-Bretagne font pression à l’ONU sur la Syrie

7 juin 2011 20:00
Football: le milieu de Sunderland Jordan Henderson à Liverpool
6 juin 2011 20:00
Allemagne : La bactérie E. coli progresse moins mais l''enquête piétine

5 juin 2011 20:00
L’armée israélienne ouvre le feu sur des palestiniens sur le Golan

5 juin 2011 20:00
